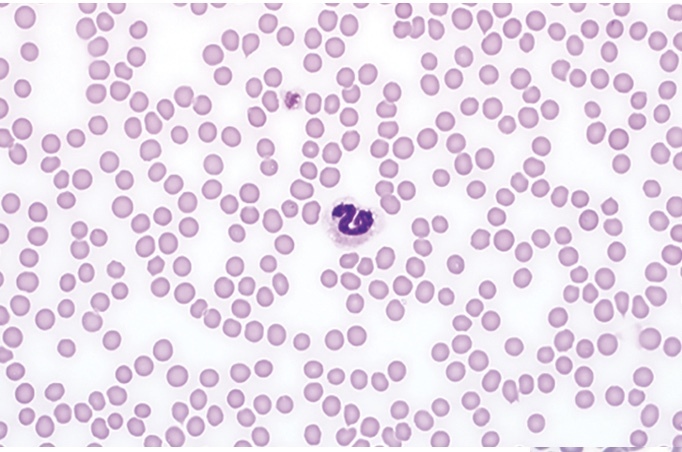
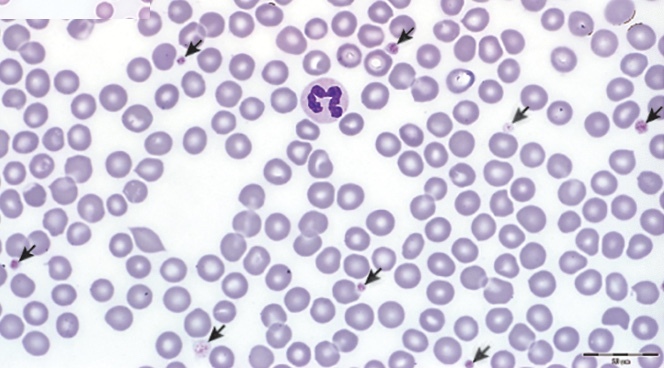
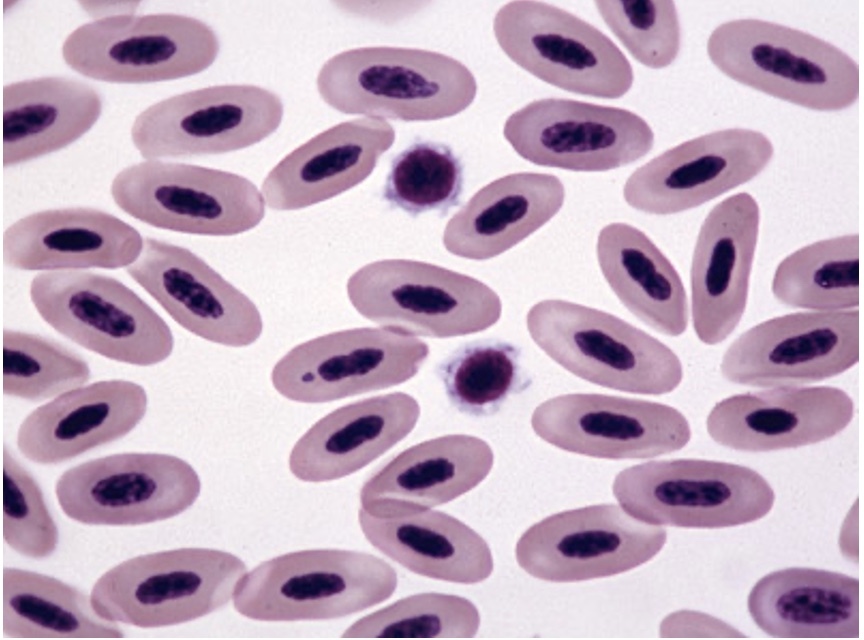

mechanism to form blood clot at site of vessel damage
hemostasis
blood clot at site of vessel damage
thrombosis
blood clot that travels to a different location
embolus
2 parts of primary hemostasis
vascular wall
platelets
secondary hemostasis
coagulation cascade
vessel wall damage triggers what
sympathetic vasoconstriction
clot formation (2 main steps)
platelet activation
fibrin formation
plasma protein produced by EC’s and bind platelets
vWF (von willebrand factor)
normal blood smear, no platelets
arrows point to
platelets
normal parrot RBC’s
epi, collagen, thrombin, ADP, TXA2
important for platelet activation
what happens with platelets that leads to degranulation
shape changes
what determines successful degranulation
TXA2 formation from cyclooxygenase (COX)
blocks platelets from forming mature platelet plug
Aspirin
contents that platelets release during degranulation
vWF, fibrinogen, Factor V, ATP
what is required for platelets to aggregate
fibrinogen binding to platelet surface receptor GPIIb/IIIa
defect in GPIIb/IIIa and causes people to bleed
Glanzmann thrombasthenia (GT)
without this complex, can’t form platelet plug
GPIIb/IIIa
what can also activate platelets
sepsis
atheroma formation when macrophages can’t break down cholesterol; platelets come to damaged EC; vWF binds GP IIb/IIIa—> fibrinogen released, coagulation cascade—> more solid clot formed
cross talk b/t WBC’s and platelets
one leg larger than the other; erythema; warm; hurts to squeeze calf
deep vein thrombosis
what is the fear for deep vein thrombosis
pulmonary embolism
why is it red?

RBC’s trapped in platelet/fibrin net


